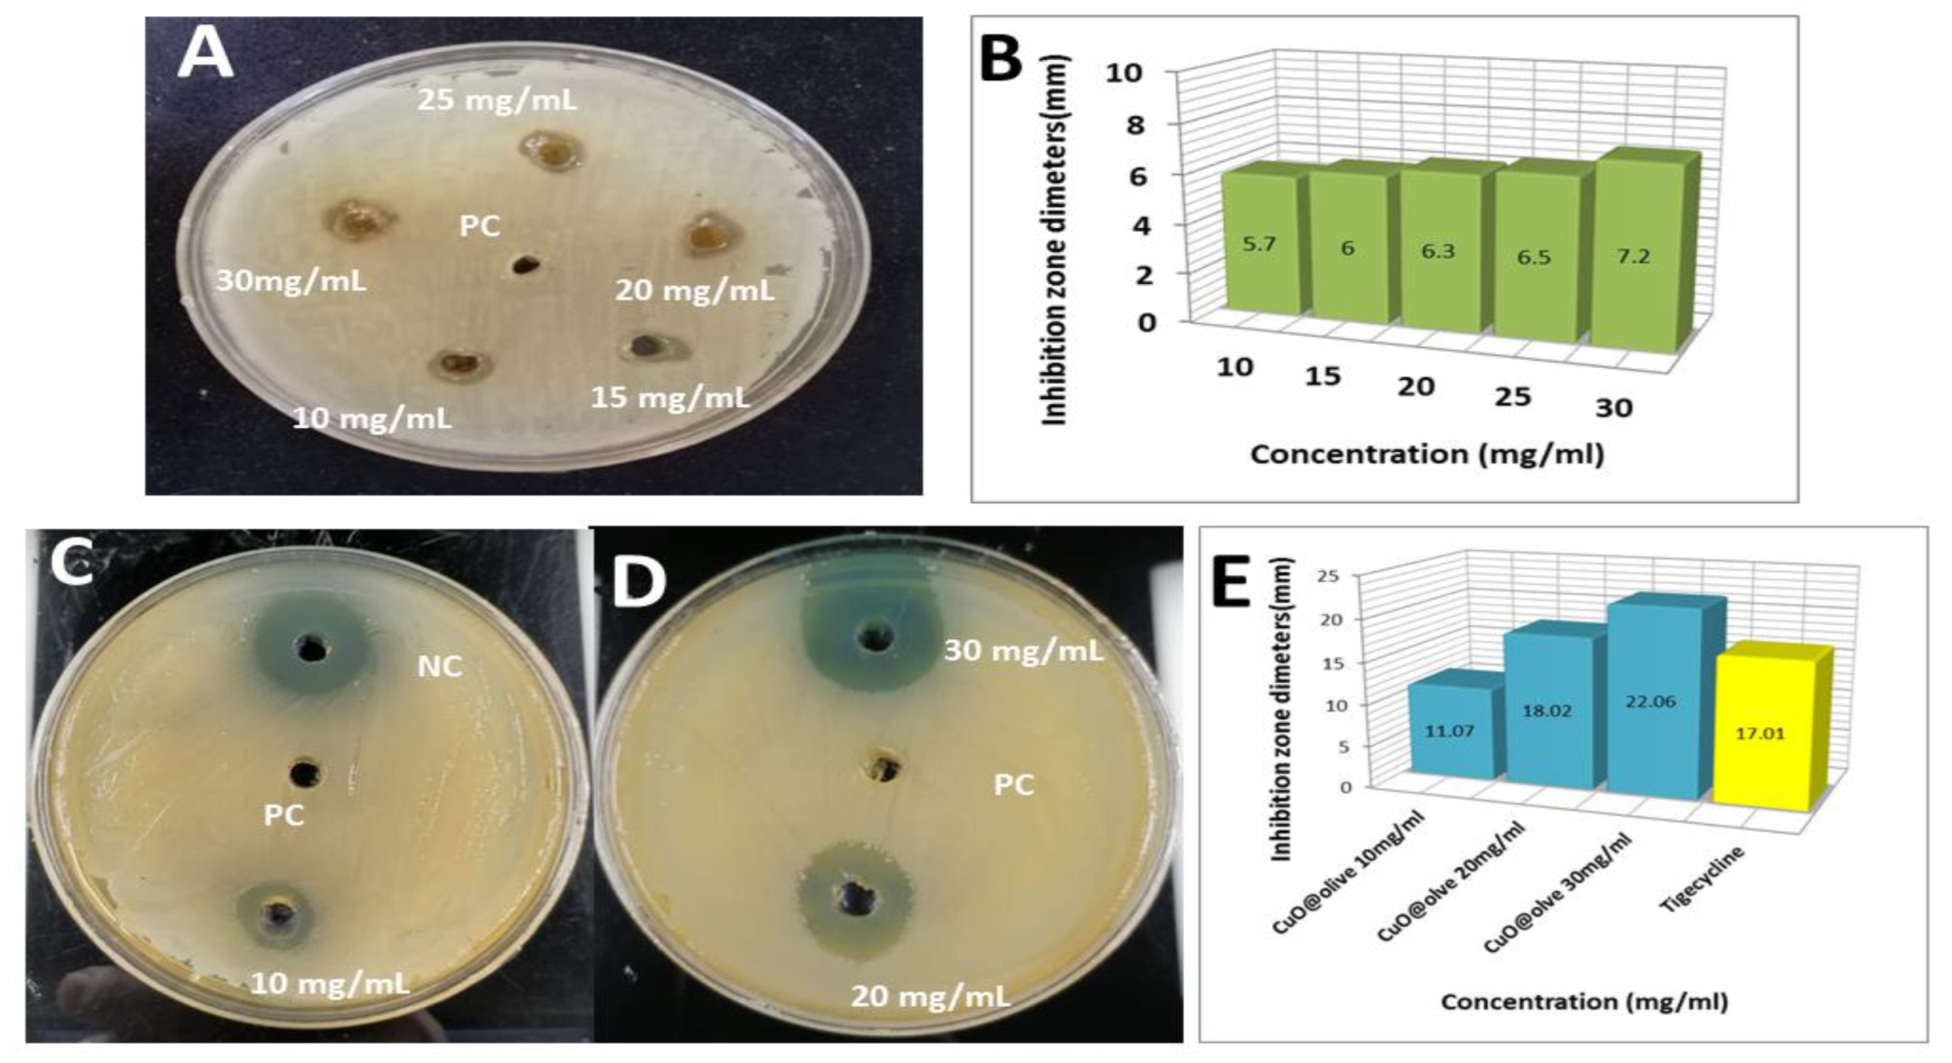
Molecules 27 07957 g007 Molecules 27 07957 g007

Novel Copper Oxide Bio-Nanocrystals to Target Outer Membrane Lectin of Vancomycin-Resistant Enterococcus faecium (VREfm): In Silico, Bioavailability, Antimicrobial, and Anticancer Potential
Abstract
1. Introduction
2. Results and Discussion
2.1. Role of Phyto-Reductants and Capping of OVLe Agents for Tailoring and Characterization of OVLe@CuO NCs
2.1.1. UV-Vis Absorption Spectroscopy Analysis
2.1.2. FTIR Analysis
2.1.3. XRD Analysis
2.1.4. Surface Morphology
2.2. Antibacterial Potential of CuO @OVLe NCs
2.3. Screening Cytotoxicity Study and Anti-Cancer of CuO @OVLe NCs
2.4. Molecular Docking and Interaction of Ligands with the Active Site of Enterococcus faecium Lectin
2.5. Interaction Analysis of Ligand with Target EFLec
2.6. Molecular Dynamic Simulations
2.7. Ligand Torsion Profile and Properties
3. Materials and Methods
3.1. Collection Samples
3.2. Preparation of Olive Leaf Extract
3.3. Biosynthesis of CuO @OVLe NCs
3.4. Characterizations of CuO @OVLe NCs
3.5. Surface Morphology
3.6. Culture of the Microorganism
3.7. Antimicrobial Activity
3.8. Cell Lines
3.9. Cytotoxicity Activity
3.10. Molecular Docking
3.11. Interaction of Oleuropein into the Active Pocket of ECLec
3.12. Molecular Dynamics Simulations (MD Simulations)
3.13. Statistical Analysis
4. Conclusions
Supplementary Materials
Author Contributions
Funding
Institutional Review Board Statement
Informed Consent Statement
Data Availability Statement
Acknowledgments
Conflicts of Interest
Sample Availability
References
- Langdon, A.; Crook, N.; Dantas, G. The effects of antibiotics on the microbiome throughout development and alternative approaches for therapeutic modulation. Genome Med. 2016, 8, 39. [Google Scholar] [CrossRef] [PubMed]
- Hollis, A.; Ahmed, Z. The path of least resistance: Paying for antibiotics in non-human uses. Health Policy 2014, 118, 264–270. [Google Scholar] [CrossRef] [PubMed]
- Khalifa, S.A.M.; Shedid, E.S.; Saied, E.M.; Jassbi, A.R.; Jamebozorgi, F.H.; Rateb, M.E.; Du, M.; Abdel-Daim, M.M.; Kai, G.-Y.; Al-Hammady, M.A.M.; et al. Cyanobacteria—From the Oceans to the Potential Biotechnological and Biomedical Applications. Mar. Drugs 2021, 19, 241. [Google Scholar] [CrossRef]
- Koch-Edelmann, S.; Banhart, S.; Saied, E.M.; Rose, L.; Aeberhard, L.; Laue, M.; Doellinger, J.; Arenz, C.; Heuer, D. The cellular ceramide transport protein CERT promotes Chlamydia psittaci infection and controls bacterial sphingolipid uptake. Cell. Microbiol. 2017, 19, e12752. [Google Scholar] [CrossRef] [PubMed]
- Saied, E.M.; Banhart, S.; Burkle, S.E.; Heuer, D.; Arenz, C. A series of ceramide analogs modified at the 1-position with potent activity against the intracellular growth of Chlamydia trachomatis. Future Med. Chem. 2015, 7, 1971–1980. [Google Scholar] [CrossRef]
- Banhart, S.; Saied, E.M.; Martini, A.; Koch, S.; Aeberhard, L.; Madela, K.; Arenz, C.; Heuer, D. Improved plaque assay identifies a novel anti-Chlamydia ceramide derivative with altered intracellular localization. Antimicrob. Agents Chemother. 2014, 58, 5537–5546. [Google Scholar] [CrossRef]
- de Been, M.; van Schaik, W.; Cheng, L.; Corander, J.; Willems, R.J. Recent recombination events in the core genome are associated with adaptive evolution in Enterococcus faecium. Genome Biol. Evol. 2013, 5, 1524–1535. [Google Scholar] [CrossRef]
- Johnson, A.P. The pathogenicity of enterococci. J. Antimicrob. Chemother. 1994, 33, 1083–1089. [Google Scholar] [CrossRef]
- Weng, P.L.; Hamat, R.A.; Kqueen, Y.; Zainol, N.; Aziz, M.N.; Shamsudin, M.N. Vancomycin-resistant Enterococcus faecium of multi-locus sequence type 18 in Malaysia. Med. J. Malays. 2012, 67, 639–640. [Google Scholar]
- Chen, C.; Sun, J.; Guo, Y.; Lin, D.; Guo, Q.; Hu, F.; Zhu, D.; Xu, X.; Wang, M. High prevalence of vanM in vancomycin-resistant Enterococcus faecium isolates from Shanghai, China. Antimicrob. Agents Chemother. 2015, 59, 7795–7798. [Google Scholar] [CrossRef]
- Franz, C.M.; Huch, M.; Abriouel, H.; Holzapfel, W.; Gálvez, A. Enterococci as probiotics and their implications in food safety. Int. J. Food Microbiol. 2011, 151, 125–140. [Google Scholar] [CrossRef] [PubMed]
- Brueggemann, A.B.; Pai, R.; Crook, D.W.; Beall, B. Vaccine escape recombinants emerge after pneumococcal vaccination in the United States. PLoS Pathog. 2007, 3, e168. [Google Scholar] [CrossRef] [PubMed]
- Vazquez-Muñoz, R.; Meza-Villezcas, A.; Fournier, P.; Soria-Castro, E.; Juarez-Moreno, K.; Gallego-Hernández, A.; Bogdanchikova, N.; Vazquez-Duhalt, R.; Huerta-Saquero, A. Enhancement of antibiotics antimicrobial activity due to the silver nanoparticles impact on the cell membrane. PLoS ONE 2019, 14, e0224904. [Google Scholar] [CrossRef] [PubMed]
- Edeoga, H.O.; Okwu, D.; Mbaebie, B. Phytochemical constituents of some Nigerian medicinal plants. Afr. J. Biotechnol. 2005, 4, 685–688. [Google Scholar] [CrossRef]
- Meyer, M.S.; Joshipura, K.; Giovannucci, E.; Michaud, D.S. A review of the relationship between tooth loss, periodontal disease, and cancer. Cancer Causes Control 2008, 19, 895–907. [Google Scholar] [CrossRef]
- Sohn, B.; Cohen, R. Processible optically transparent block copolymer films containing superparamagnetic iron oxide nanoclusters. Chem. Mater. 1997, 9, 264–269. [Google Scholar] [CrossRef]
- Sharaf, M.; Sewid, A.H.; Hamouda, H.; Elharrif, M.G.; El-Demerdash, A.S.; Alharthi, A.; Hashim, N.; Hamad, A.A.; Selim, S.; Alkhalifah, D.H.M. Rhamnolipid-Coated Iron Oxide Nanoparticles as a Novel Multitarget Candidate against Major Foodborne E. coli Serotypes and Methicillin-Resistant S. aureus. Microbiol. Spectr. 2022, 10, e00250-22. [Google Scholar] [CrossRef]
- Salata, O.V. Applications of nanoparticles in biology and medicine. J. Nanobiotechnol. 2004, 2, 3. [Google Scholar] [CrossRef]
- Boss, A.; Bishop, K.S.; Marlow, G.; Barnett, M.P.; Ferguson, L.R. Evidence to support the anti-cancer effect of olive leaf extract and future directions. Nutrients 2016, 8, 513. [Google Scholar] [CrossRef]
- Hassen, I.; Casabianca, H.; Hosni, K. Biological activities of the natural antioxidant oleuropein: Exceeding the expectation–A mini-review. J. Funct. Foods 2015, 18, 926–940. [Google Scholar] [CrossRef]
- Lins, P.G.; Pugine, S.M.P.; Scatolini, A.M.; de Melo, M.P. In vitro antioxidant activity of olive leaf extract (Olea europaea L.) and its protective effect on oxidative damage in human erythrocytes. Heliyon 2018, 4, e00805. [Google Scholar] [CrossRef] [PubMed]
- Acar-Tek, N.; Ağagündüz, D. Olive leaf (Olea europaea L. folium): Potential effects on Glycemia and Lipidemia. Ann. Nutr. Metab. 2020, 76, 10–15. [Google Scholar] [CrossRef] [PubMed]
- El, S.N.; Karakaya, S. Olive tree (Olea europaea) leaves: Potential beneficial effects on human health. Nutr. Rev. 2009, 67, 632–638. [Google Scholar] [CrossRef] [PubMed]
- Sulaiman, G.M.; Tawfeeq, A.T.; Jaaffer, M.D. Biogenic synthesis of copper oxide nanoparticles using Olea europaea leaf extract and evaluation of their toxicity activities: An in vivo and in vitro study. Biotechnol. Prog. 2018, 34, 218–230. [Google Scholar] [CrossRef]
- Mary, M.G.A. Green synthesis of copper nanoparticles using eclipta prostrata leaves extract and their impact on seed germination and seedling growth of sorghum vulgare. Galaxy Int. Interdiscip. Res. J. 2021, 9, 168–186. [Google Scholar]
- Alshawwa, S.Z.; Mohammed, E.J.; Hashim, N.; Sharaf, M.; Selim, S.; Alhuthali, H.M.; Alzahrani, H.A.; Mekky, A.E.; Elharrif, M.G. In Situ Biosynthesis of Reduced Alpha Hematite (α-Fe2O3) Nanoparticles by Stevia rebaudiana L. Leaf Extract: Insights into Antioxidant, Antimicrobial, and Anticancer Properties. Antibiotics 2022, 11, 1252. [Google Scholar] [CrossRef]
- Hou, Y.; Kovács, N.; Xu, H.; Sun, C.; Erni, R.; Gálvez-Vázquez, M.d.; Rieder, A.; Hu, H.; Kong, Y.; Liu, M. Limitations of identical location SEM as a method of degradation studies on surfactant capped nanoparticle electrocatalysts. J. Catal. 2021, 394, 58–66. [Google Scholar] [CrossRef]
- Dipankar, C.; Murugan, S. The green synthesis, characterization and evaluation of the biological activities of silver nanoparticles synthesized from Iresine herbstii leaf aqueous extracts. Colloids Surf. B Biointerfaces 2012, 98, 112–119. [Google Scholar] [CrossRef]
- Selim, M.S.; Hamouda, H.; Hao, Z.; Shabana, S.; Chen, X. Design of γ-AlOOH, γ-MnOOH, and α-Mn2O3 nanorods as advanced antibacterial active agents. Dalton Trans. 2020, 49, 8601–8613. [Google Scholar] [CrossRef]
- Gaber, A.; Refat, M.S.; Belal, A.A.M.; El-Deen, I.M.; Hassan, N.; Zakaria, R.; Alhomrani, M.; Alamri, A.S.; Alsanie, W.F.; Saied, E.M. New Mononuclear and Binuclear Cu(II), Co(II), Ni(II), and Zn(II) Thiosemicarbazone Complexes with Potential Biological Activity: Antimicrobial and Molecular Docking Study. Molecules 2021, 26, 2288. [Google Scholar] [CrossRef]
- Wang, Y.; Wu, Y.; Quadri, F.; Prox, J.D.; Guo, L. Cytotoxicity of ZnO nanowire arrays on excitable cells. Nanomaterials 2017, 7, 80. [Google Scholar] [CrossRef] [PubMed]
- Berridge, M.V.; Tan, A.S. Characterization of the cellular reduction of 3-(4,5-dimethylthiazol-2-yl)-2,5-diphenyltetrazolium bromide (MTT): Subcellular localization, substrate dependence, and involvement of mitochondrial electron transport in MTT reduction. Arch. Biochem. Biophys. 1993, 303, 474–482. [Google Scholar] [CrossRef] [PubMed]
- Gaber, A.; Alsanie, W.F.; Kumar, D.N.; Refat, M.S.; Saied, E.M. Novel Papaverine Metal Complexes with Potential Anticancer Activities. Molecules 2020, 25, 5447. [Google Scholar] [CrossRef] [PubMed]
- Abdel-Wahab, B.A.; El-Kareem, H.F.A.; Alzamami, A.; Fahmy, C.A.; Elesawy, B.H.; Mahmoud, M.M.; Ghareeb, A.; el Askary, A.; Nahas, H.H.A.; Attallah, N.G.M.; et al. Novel Exopolysaccharide from Marine Bacillus subtilis with Broad Potential Biological Activities: Insights into Antioxidant, Anti-Inflammatory, Cytotoxicity, and Anti-Alzheimer Activity. Metabolites 2022, 12, 715. [Google Scholar] [CrossRef] [PubMed]
- Kim, S.; Chen, J.; Cheng, T.; Gindulyte, A.; He, J.; He, S.; Li, Q.; Shoemaker, B.A.; Thiessen, P.A.; Yu, B.; et al. PubChem 2019 update: Improved access to chemical data. Nucleic Acids Res. 2019, 47, D1102–D1109. [Google Scholar] [CrossRef] [PubMed]
- Fong, Y.H.; Wong, H.C.; Yuen, M.H.; Lau, P.H.; Chen, Y.W.; Wong, K.B. Structure of UreG/UreF/UreH complex reveals how urease accessory proteins facilitate maturation of Helicobacter pylori urease. PLoS Biol. 2013, 11, e1001678. [Google Scholar] [CrossRef] [PubMed]
- Trott, O.; Olson, A.J. AutoDock Vina: Improving the speed and accuracy of docking with a new scoring function, efficient optimization, and multithreading. J. Comput. Chem. 2010, 31, 455–461. [Google Scholar] [CrossRef]
- Alameen, A.A.; Abdalla, M.; Alshibl, H.M.; AlOthman, M.R.; Alkhulaifi, M.M.; Mirgany, T.O.; Elsayim, R. In-silico studies of glutathione peroxidase4 activators as candidate for multiple sclerosis management. J. Saudi Chem. Soc. 2022, 26, 101554. [Google Scholar] [CrossRef]
- Healey, R.D.; Saied, E.M.; Cong, X.; Karsai, G.; Gabellier, L.; Saint-Paul, J.; del Nero, E.; Jeannot, S.; Drapeau, M.; Fontanel, S.; et al. Discovery and Mechanism of Action of Small Molecule Inhibitors of Ceramidases. Angew. Chem. Int. Ed. Engl. 2022, 61, e202109967. [Google Scholar] [CrossRef]
- Khirallah, S.M.; Ramadan, H.M.M.; Shawky, A.; Qahl, S.H.; Baty, R.S.; Alqadri, N.; Alsuhaibani, A.M.; Jaremko, M.; Emwas, A.H.; Saied, E.M. Development of Novel 1,3-Disubstituted-2-Thiohydantoin Analogues with Potent Anti-Inflammatory Activity; In Vitro and In Silico Assessments. Molecules 2022, 27, 6271. [Google Scholar] [CrossRef]
- Salem, M.G.; El-Maaty, D.M.A.; El-Deen, Y.I.M.; Elesawy, B.H.; Askary, A.E.; Saleh, A.; Saied, E.M.; Behery, M.E. Novel 1,3-Thiazole Analogues with Potent Activity against Breast Cancer: A Design, Synthesis, In Vitro, and In Silico Study. Molecules 2022, 27, 4898. [Google Scholar] [CrossRef] [PubMed]
- Saied, E.M.; El-Maradny, Y.A.; Osman, A.A.; Darwish, A.M.G.; Nahas, H.H.A.; Niedbała, G.; Piekutowska, M.; Abdel-Rahman, M.A.; Balbool, B.A.; Abdel-Azeem, A.M. A Comprehensive Review about the Molecular Structure of Severe Acute Respiratory Syndrome Coronavirus 2 (SARS-CoV-2): Insights into Natural Products against COVID-19. Pharmaceutics 2021, 13, 1759. [Google Scholar] [CrossRef] [PubMed]
- Mohamed, D.I.; El-Waseef, D.A.E.A.; Nabih, E.S.; El-Kharashi, O.A.; El-Kareem, H.F.A.; Nahas, H.H.A.; Abdel-Wahab, B.A.; Helmy, Y.A.; Alshawwa, S.Z.; Saied, E.M. Acetylsalicylic Acid Suppresses Alcoholism-Induced Cognitive Impairment Associated with Atorvastatin Intake by Targeting Cerebral miRNA155 and NLRP3: In Vivo, and In Silico Study. Pharmaceutics 2022, 14, 529. [Google Scholar] [CrossRef] [PubMed]
- el Azab, I.H.; Saied, E.M.; Osman, A.A.; Mehana, A.E.; Saad, H.A.; Elkanzi, N.A. Novel N-bridged pyrazole-1-carbothioamides with potential antiproliferative activity: Design, synthesis, in vitro and in silico studies. Future Med. Chem. 2021, 13, 1743–1766. [Google Scholar] [CrossRef] [PubMed]
- Samaha, D.; Hamdo, H.H.; Cong, X.; Schumacher, F.; Banhart, S.; Aglar, O.; Moller, H.M.; Heuer, D.; Kleuser, B.; Saied, E.M.; et al. Liposomal FRET Assay Identifies Potent Drug-Like Inhibitors of the Ceramide Transport Protein (CERT). Chemistry 2020, 26, 16616–16621. [Google Scholar] [CrossRef] [PubMed]
- Daina, A.; Michielin, O.; Zoete, V. SwissADME: A free web tool to evaluate pharmacokinetics, drug-likeness and medicinal chemistry friendliness of small molecules. Sci. Rep. 2017, 7, 42717. [Google Scholar] [CrossRef]
- Biovia, D.S. Discovery Studio Modeling Environment, Release, 2017; Dassault Systèmes: San Diego, CA, USA, 2017. [Google Scholar]
- DeLano, W.L. The PyMOL Molecular Graphics System; Delano Scientific: San Carlos, CA, USA, 2002. [Google Scholar]
- Sharaf, M.; Arif, M.; Hamouda, H.I.; Khan, S.; Abdalla, M.; Shabana, S.; Rozan, H.E.; Khan, T.U.; Chi, Z.; Liu, C. Preparation, urease inhibition mechanisms, and anti-Helicobacter pylori activities of hesperetin-7-rhamnoglucoside. Curr. Res. Microb. Sci. 2022, 3, 100103. [Google Scholar] [CrossRef]
- Laskowski, R.A. PDBsum new things. Nucleic Acids Res. 2009, 37, D355–D359. [Google Scholar] [CrossRef]
- Mou, K.; Abdalla, M.; Wei, D.Q.; Khan, M.T.; Lodhi, M.S.; Darwish, D.B.; Sharaf, M.; Tu, X. Emerging mutations in envelope protein of SARS-CoV-2 and their effect on thermodynamic properties. Inform. Med. Unlocked 2021, 25, 100675. [Google Scholar] [CrossRef]
- Abraham, M.J.; Murtola, T.; Schulz, R.; Páll, S.; Smith, J.C.; Hess, B.; Lindahl, E. GROMACS: High performance molecular simulations through multi-level parallelism from laptops to supercomputers. SoftwareX 2015, 1, 19–25. [Google Scholar] [CrossRef]
- Mark, P.; Nilsson, L. Structure and dynamics of the TIP3P, SPC, and SPC/E water models at 298 K. J. Phys. Chem. A 2001, 105, 9954–9960. [Google Scholar] [CrossRef]
- Mohamed, D.I.; Ezzat, S.F.; Elayat, W.M.; El-Kharashi, O.A.; El-Kareem, H.F.A.; Nahas, H.H.A.; Abdel-Wahab, B.A.; Alshawwa, S.Z.; Saleh, A.; Helmy, Y.A.; et al. Hepatoprotective Role of Carvedilol against Ischemic Hepatitis Associated with Acute Heart Failure via Targeting miRNA-17 and Mitochondrial Dynamics-Related Proteins: An In Vivo and In Silico Study. Pharmaceuticals 2022, 15, 832. [Google Scholar] [CrossRef] [PubMed]
- Mohamed, D.I.; Abou-Bakr, D.A.; Ezzat, S.F.; El-Kareem, H.F.A.; Nahas, H.H.A.; Saad, H.A.; Mehana, A.E.; Saied, E.M. Vitamin D3 Prevents the Deleterious Effects of Testicular Torsion on Testis by Targeting miRNA-145 and ADAM17: In Silico and In Vivo Study. Pharmaceuticals 2021, 14, 1222. [Google Scholar] [CrossRef] [PubMed]
- Maqbool, Q.; Nazar, M.; Maqbool, A.; Pervez, M.T.; Jabeen, N.; Hussain, T.; Franklin, G. CuO and CeO2 nanostructures green synthesized using olive leaf extract inhibits the growth of highly virulent multidrug resistant bacteria. Front. Pharmacol. 2018, 9, 987. [Google Scholar] [CrossRef]
- Lim, A.; Subhan, N.; Jazayeri, J.; John, G.; Vanniasinkam, T.; Obied, H. Plant phenols as antibiotic boosters In vitro interaction of olive leaf phenols with ampicillin. Phytother Res. 2016, 30, 503–509. [Google Scholar] [CrossRef]
- Maqbool, Q.; Nazar, M.; Naz, S.; Hussain, T.; Jabeen, N.; Kausar, R.; Anwaar, S.; Abbas, F.; Jan, T. Antimicrobial potential of green synthesized CeO2 nanoparticles from Olea europaea leaf extract. Int. J. Nanomed. 2016, 11, 5015. [Google Scholar] [CrossRef]
- Aziz, W.J.; Abid, M.A.; Hussein, E.H. Biosynthesis of CuO nanoparticles and synergistic antibacterial activity using mint leaf extract. Mater. Technol. 2020, 35, 447–451. [Google Scholar] [CrossRef]
- Mahmoud, A.E.D.; Al-Qahtani, K.M.; Alflaij, S.O.; Al-Qahtani, S.F.; Alsamhan, F.A. Green copper oxide nanoparticles for lead, nickel, and cadmium removal from contaminated water. Sci. Rep. 2021, 11, 12547. [Google Scholar] [CrossRef]
- Khalil, M.M.; Ismail, E.H.; El-Magdoub, F. Biosynthesis of Au nanoparticles using olive leaf extract: 1st nano updates. Arab. J. Chem. 2012, 5, 431–437. [Google Scholar] [CrossRef]
- Zayyoun, N.; Bahmad, L.; Laânab, L.; Jaber, B. The effect of pH on the synthesis of stable Cu2O/CuO nanoparticles by sol–gel method in a glycolic medium. Appl. Phys. A 2016, 122, 488. [Google Scholar] [CrossRef]
- Maqbool, Q. Green-synthesised cerium oxide nanostructures (CeO2-NS) show excellent biocompatibility for phyto-cultures as compared to silver nanostructures (Ag-NS). RSC Adv. 2017, 7, 56575–56585. [Google Scholar] [CrossRef]
- Siddiqui, H.; Parra, M.R.; Qureshi, M.; Malik, M.; Haque, F.Z. Studies of structural, optical, and electrical properties associated with defects in sodium-doped copper oxide (CuO/Na) nanostructures. J. Mater. Sci. 2018, 53, 8826–8843. [Google Scholar] [CrossRef]
- Padil, V.V.T.; Černík, M. Green synthesis of copper oxide nanoparticles using gum karaya as a biotemplate and their antibacterial application. Int. J. Nanomed. 2013, 8, 889–898. [Google Scholar]
- Adhikari, T.; Dube, G.; Kundu, S.; Patra, A. Impact of Copper Oxide Nanoparticles on Growth of Different Bacterial Species, Energy and Environment; Springer: Berlin/Heidelberg, Germany, 2018; pp. 47–55. [Google Scholar]
- Yrken, Z. Minimum inhibitory concentration values and problematic disk break points of tigecycline against vancomycin and/or high-level aminoglycoside-resistant enterococci. Alex. J. Med. 2019, 52, 125–129. [Google Scholar]
- Maalej, A.; Bouallagui, Z.; Hadrich, F.; Isoda, H.; Sayadi, S. Assessment of Olea europaea L. fruit extracts: Phytochemical characterization and anticancer pathway investigation. Biomed. Pharmacother. 2017, 90, 179–186. [Google Scholar] [CrossRef] [PubMed]
- Withers, P.J.; van Dijk, K.C.; Neset, T.-S.S.; Nesme, T.; Oenema, O.; Rubæk, G.H.; Schoumans, O.F.; Smit, B.; Pellerin, S. Stewardship to tackle global phosphorus inefficiency: The case of Europe. Ambio 2015, 44, 193–206. [Google Scholar] [CrossRef] [PubMed]
- Wang, L.; Hu, C.; Shao, L. The antimicrobial activity of nanoparticles: Present situation and prospects for the future. Int. J. Nanomed. 2017, 12, 1227. [Google Scholar] [CrossRef]
- Wang, S.; Cazelles, R.; Liao, W.-C.; Vázquez-González, M.; Zoabi, A.; Abu-Reziq, R.; Willner, I. Mimicking horseradish peroxidase and NADH peroxidase by heterogeneous Cu2+-modified graphene oxide nanoparticles. Nano Lett. 2017, 17, 2043–2048. [Google Scholar] [CrossRef] [PubMed]
- Li, Y.; Niu, J.; Shang, E.; Crittenden, J.C. Influence of dissolved organic matter on photogenerated reactive oxygen species and metal-oxide nanoparticle toxicity. Water Res. 2016, 98, 9–18. [Google Scholar] [CrossRef]
- Kung, M.-L.; Tai, M.-H.; Lin, P.-Y.; Wu, D.-C.; Wu, W.-J.; Yeh, B.-W.; Hung, H.-S.; Kuo, C.-H.; Chen, Y.-W.; Hsieh, S.-L. Silver decorated copper oxide (Ag@ CuO) nanocomposite enhances ROS-mediated bacterial architecture collapse. Colloids Surf. B Biointerfaces 2017, 155, 399–407. [Google Scholar] [CrossRef]
- Kelly, K.L.; Coronado, E.; Zhao, L.L.; Schatz, G.C. The Optical Properties of Metal Nanoparticles: The Influence of Size, Shape, and Dielectric Environment; ACS Publications: Washington, DC, USA, 2003; pp. 668–677. [Google Scholar]
- Alishah, H.; Pourseyedi, S.; Ebrahimipour, S.Y.; Mahani, S.E.; Rafiei, N. Green synthesis of starch-mediated CuO nanoparticles: Preparation, characterization, antimicrobial activities and in vitro MTT assay against MCF-7 cell line. Rend. Lincei 2017, 28, 65–71. [Google Scholar] [CrossRef]
- Jinu, U.; Gomathi, M.; Saiqa, I.; Geetha, N.; Benelli, G.; Venkatachalam, P. Green engineered biomolecule-capped silver and copper nanohybrids using Prosopis cineraria leaf extract: Enhanced antibacterial activity against microbial pathogens of public health relevance and cytotoxicity on human breast cancer cells (MCF-7). Microb. Pathog. 2017, 105, 86–95. [Google Scholar] [CrossRef] [PubMed]
- Sharma, P.; Goyal, D.; Baranwal, M.; Chudasama, B. ROS-induced cytotoxicity of colloidal copper nanoparticles in MCF-7 human breast cancer cell line: An in vitro study. J. Nanopart. Res. 2020, 22, 244. [Google Scholar] [CrossRef]
- Biresaw, S.S.; Taneja, P. Copper nanoparticles green synthesis and characterization as anticancer potential in breast cancer cells (MCF7) derived from Prunus nepalensis phytochemicals. Mater. Today Proc. 2022, 49, 3501–3509. [Google Scholar] [CrossRef]
- Fu, X. Oxidative stress induced by CuO nanoparticles (CuO NPs) to human hepatocarcinoma (HepG2) cells. J. Cancer Ther. 2015, 6, 889. [Google Scholar] [CrossRef]
- Devipriya, D.; Roopan, S.M. Cissus quadrangularis mediated ecofriendly synthesis of copper oxide nanoparticles and its antifungal studies against Aspergillus niger, Aspergillus flavus. Mater. Sci. Eng. C 2017, 80, 38–44. [Google Scholar] [CrossRef]
- Zhang, S.; Wang, Y.; Song, H.; Lu, J.; Yuan, Z.; Guo, J. Copper nanoparticles and copper ions promote horizontal transfer of plasmid-mediated multi-antibiotic resistance genes across bacterial genera. Environ. Int. 2019, 129, 478–487. [Google Scholar] [CrossRef]
- Abbas, S.; Nasreen, S.; Haroon, A.; Ashraf, M.A. Synhesis of silver and copper nanoparticles from plants and application as adsorbents for naphthalene decontamination. Saudi J. Biol. Sci. 2020, 27, 1016–1023. [Google Scholar] [CrossRef]
- Delatorre, P.; Silva-Filho, J.C.; Rocha, B.A.M.; Santi-Gadelha, T.; da Nóbrega, R.B.; Gadelha, C.A.A.; Nascimento, K.S.D.; Nagano, C.S.; Sampaio, A.H.; Cavada, B.S. Interactions between indole-3-acetic acid (IAA) with a lectin from Canavalia maritima seeds reveal a new function for lectins in plant physiology. Biochimie 2013, 95, 1697–1703. [Google Scholar] [CrossRef]
- Shetty, K.N.; Latha, V.L.; Rao, R.N.; Nadimpalli, S.K.; Suguna, K. Affinity of a galactose-specific legume lectin from Dolichos lablab to adenine revealed by X-ray cystallography. IUBMB Life 2013, 65, 633–644. [Google Scholar] [CrossRef]
- Rocha, B.A.; Teixeira, C.S.; Silva-Filho, J.C.; Nóbrega, R.B.; Alencar, D.B.; Nascimento, K.S.; Freire, V.N.; Gottfried, C.J.; Nagano, C.S.; Sampaio, A.H. Structural basis of ConM binding with resveratrol, an anti-inflammatory and antioxidant polyphenol. Int. J. Biol. Macromol. 2015, 72, 1136–1142. [Google Scholar] [CrossRef] [PubMed]

| VREfm Zone of Inhibition (mm) | |||
|---|---|---|---|
| Treatment | Inhibition Zone | Treatment | Inhibition Zone |
| OLVe 10 mg/mL | 5.7 | CuO@ OLVe 10 mg/mL | 11.07 |
| OLVe 15 mg/mL | 6 | CuO@ OLVe 20 mg/mL | 18.02 |
| OLVe 20 mg/mL | 6.3 | CuO@ OLVe 30 mg/mL | 22.06 |
| OLVe 25 mg/mL | 6.5 | Negative Control (Tigecyline, 25 µg/mL) | 17.01 |
| OLVe 30 mg/mL | 7.2 | Positive Control | NI |
| Ligand | Receptor/Amino Acid | Interaction Distance | E (kcal/mol) |
|---|---|---|---|
| O7/17 | OG1/Thr244 | H-donor 2.75 | −1.2 |
| O4/19 | NE2/Gln305 | H-acceptor 2.83 | −2.5 |
| O3/21 | NE2/Gln305 | H-acceptor 3.03 | −1.2 |
| O10/27 | CA/Gly245 | H-acceptor 3.27 | −1.1 |
| O10/27 | CA/Gly258 | H-acceptor 3.49 | −0.9 |
| O11/42 | OG1/Thr257 | H-acceptor 2.82 | −2.6 |
Publisher’s Note: MDPI stays neutral with regard to jurisdictional claims in published maps and institutional affiliations. |
© 2022 by the authors. Licensee MDPI, Basel, Switzerland. This article is an open access article distributed under the terms and conditions of the Creative Commons Attribution (CC BY) license (https://creativecommons.org/licenses/by/4.0/).
Share and Cite
Kandeel, M.; Sharaf, M.; Hamad, A.M.; O. Babalghith, A.; Abdalla, M.; Arif, M.; Binsuwaidan, R.; G. M. Attallah, N.; Aladl Aladl Aladl, H.; Selim, S.; et al. Novel Copper Oxide Bio-Nanocrystals to Target Outer Membrane Lectin of Vancomycin-Resistant Enterococcus faecium (VREfm): In Silico, Bioavailability, Antimicrobial, and Anticancer Potential. Molecules 2022, 27, 7957. https://doi.org/10.3390/molecules27227957
Kandeel M, Sharaf M, Hamad AM, O. Babalghith A, Abdalla M, Arif M, Binsuwaidan R, G. M. Attallah N, Aladl Aladl Aladl H, Selim S, et al. Novel Copper Oxide Bio-Nanocrystals to Target Outer Membrane Lectin of Vancomycin-Resistant Enterococcus faecium (VREfm): In Silico, Bioavailability, Antimicrobial, and Anticancer Potential. Molecules. 2022; 27(22):7957. https://doi.org/10.3390/molecules27227957
Chicago/Turabian StyleKandeel, Mahmoud, Mohamed Sharaf, Arshad Mahdi Hamad, Ahmad O. Babalghith, Mohnad Abdalla, Muhammad Arif, Reem Binsuwaidan, Nashwah G. M. Attallah, Hossam Aladl Aladl Aladl, Samy Selim, and et al. 2022. "Novel Copper Oxide Bio-Nanocrystals to Target Outer Membrane Lectin of Vancomycin-Resistant Enterococcus faecium (VREfm): In Silico, Bioavailability, Antimicrobial, and Anticancer Potential" Molecules 27, no. 22: 7957. https://doi.org/10.3390/molecules27227957
APA StyleKandeel, M., Sharaf, M., Hamad, A. M., O. Babalghith, A., Abdalla, M., Arif, M., Binsuwaidan, R., G. M. Attallah, N., Aladl Aladl Aladl, H., Selim, S., & Jaremko, M. (2022). Novel Copper Oxide Bio-Nanocrystals to Target Outer Membrane Lectin of Vancomycin-Resistant Enterococcus faecium (VREfm): In Silico, Bioavailability, Antimicrobial, and Anticancer Potential. Molecules, 27(22), 7957. https://doi.org/10.3390/molecules27227957

